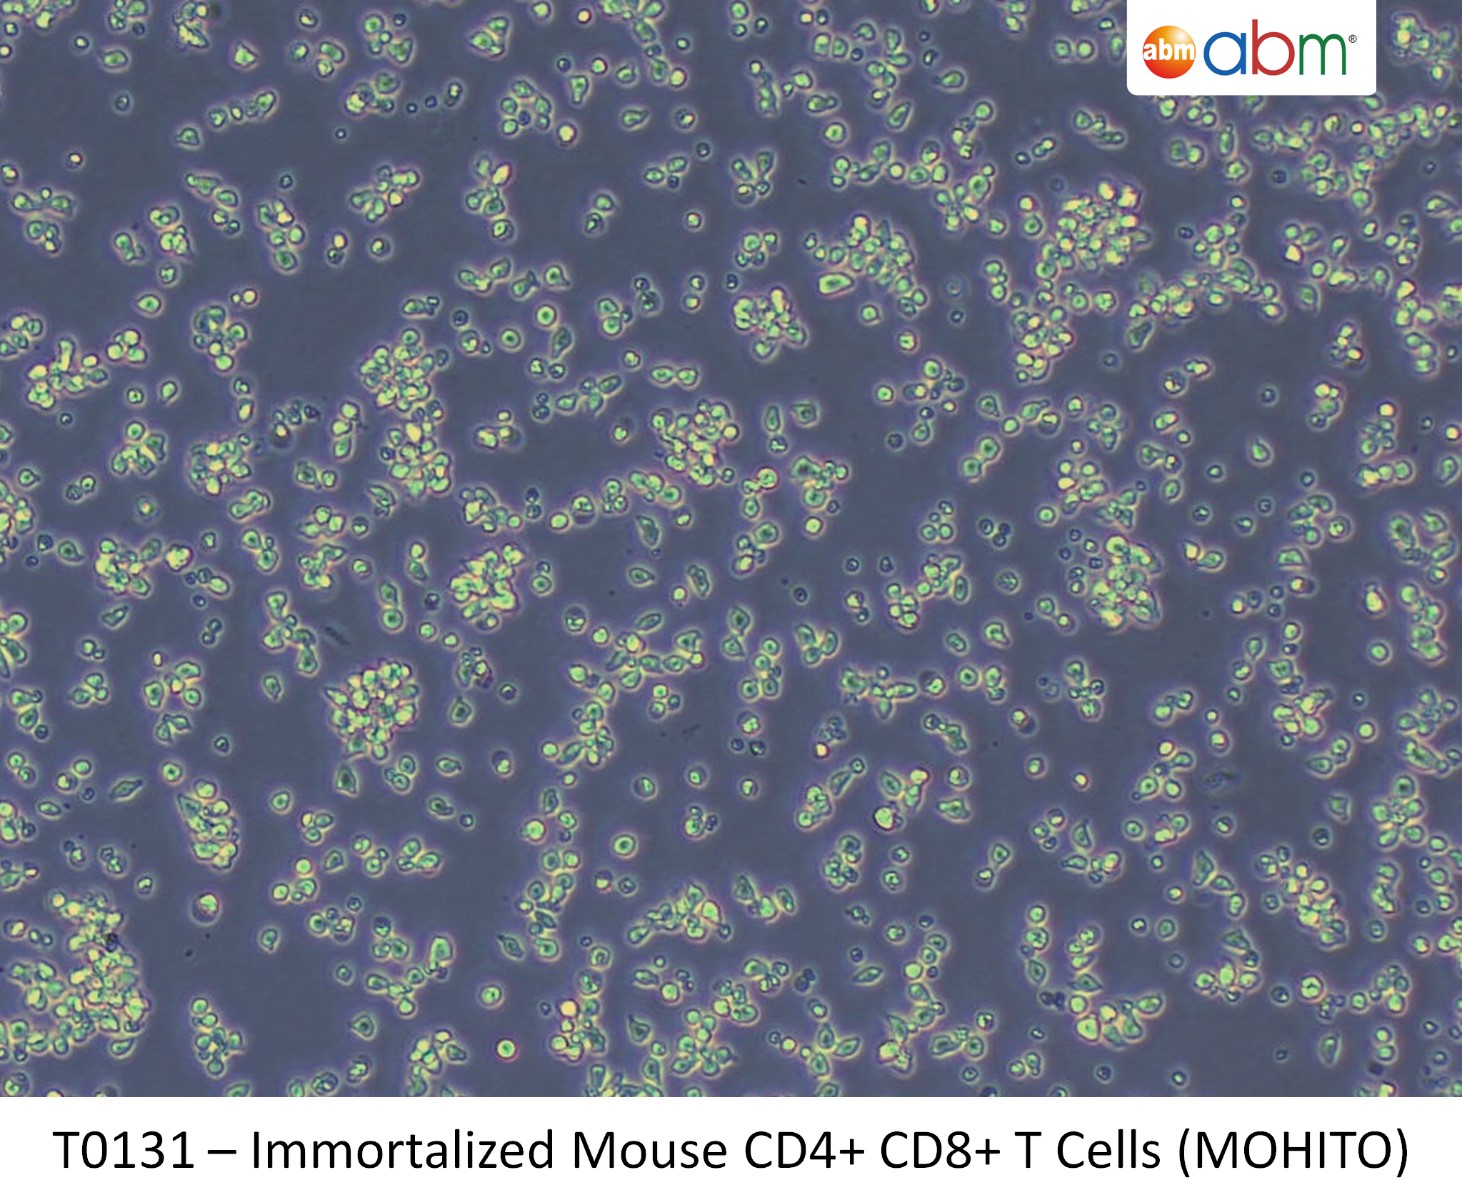
Immortalized Mouse CD4+ CD8+ T Cells (MOHITO)

Cd4/cd8 Mouse
Discover traditions with our cultural Cd4/cd8 Mouse gallery of hundreds of diverse images. celebrating diversity through photography, images, and pictures. designed to promote cultural understanding. Each Cd4/cd8 Mouse image is carefully selected for superior visual impact and professional quality. Suitable for various applications including web design, social media, personal projects, and digital content creation All Cd4/cd8 Mouse images are available in high resolution with professional-grade quality, optimized for both digital and print applications, and include comprehensive metadata for easy organization and usage. Discover the perfect Cd4/cd8 Mouse images to enhance your visual communication needs. Reliable customer support ensures smooth experience throughout the Cd4/cd8 Mouse selection process. Diverse style options within the Cd4/cd8 Mouse collection suit various aesthetic preferences. Regular updates keep the Cd4/cd8 Mouse collection current with contemporary trends and styles. Instant download capabilities enable immediate access to chosen Cd4/cd8 Mouse images. Our Cd4/cd8 Mouse database continuously expands with fresh, relevant content from skilled photographers. Multiple resolution options ensure optimal performance across different platforms and applications. The Cd4/cd8 Mouse collection represents years of careful curation and professional standards. Whether for commercial projects or personal use, our Cd4/cd8 Mouse collection delivers consistent excellence.

80502-6/asset/b2f0d72d-a18b-4a9a-a2ed-133f59bd0a83/main.assets/gr1_lrg.jpg)







































































































